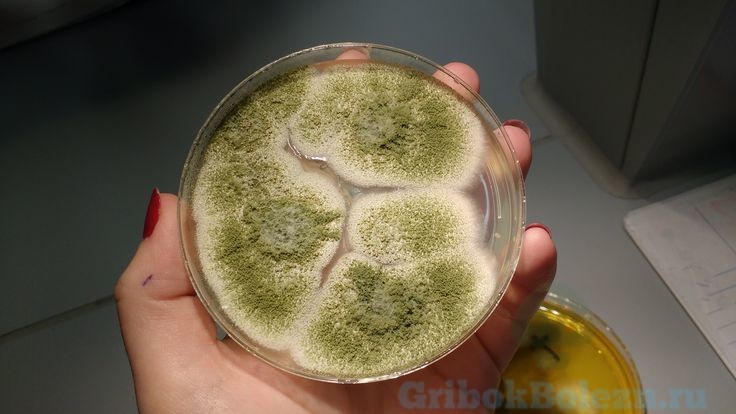
image

Насчитывается около 190 видов плесневых грибов рода Аспергилл, около 40 видов оказывают патогенное действие на организм человека и животных, вызывая инфекционные заболевания. Аспергиллус фумигатус – самый распространенный вид этого рода, обитающий на почве в органических остатках.
Ежедневно споры этого грибка вдыхает каждый человек, но инфицируются те, у кого иммунная система не в состоянии устранять патоген. Рассмотрим виды плесневых Аспергилл, потенциальную угрозу для человека и способы дезактивации этой инфекции.
Аспергиллы
Аспергиллы – это род плесневых грибов, развивающихся на органических поверхностях, обогащенных кислородом. В городской местности плесневый грибок этого рода, наблюдается на влажных стенах домов, на потолках, на разложившихся листьях, а в сельской – в открытом грунте при разложении субстрата.
Заболевания у человека вызывают несколько видов – А.фумигатус и А.флавус. Другие виды, такие как А.клаватус – способны вызвать аллергическую реакцию.
Редко встречающиеся виды Аспергилл:
- Aspergilla niger;
- Aspergilla nidulans;
- Aspergilla oruzae;
- Aspergilla terreus.
Часто аспергиллезом страдают лица, имеющие следующие характеристики:
- нарушения защитных свойств организма;
- болезни иммунной системы;
- хронические заболевания воспалительного характера;
- фермеры;
- люди, работающие на открытом грунте;
- работники птицеферм, голубятен;
- строители;
- жители первых этажей здания;
- работники канализационной службы.
Что до жильцов домов первых этажей, то при развитии плесени на стенах дома, есть риск распространения ее в жилых помещениях и заболеваний у жильцов. Чтобы этого не случилось, необходим ремонт сточных труб, обработка наружных и внутренних стен медным купоросом.
Aspergillus fumigatus – это плесневый гриб, что вызывает у человека поражение легочной ткани, брюшины, половой и центральной нервной системы.
Поражение происходит по причине нарушения функционирования иммунной системы.
Начало заражения грибками Аспергилл напоминает инфекцию дыхательных путей, имея соответствующие симптомы:
- повышение температуры тела, озноб, жар;
- кашель, затрудненное дыхание, одышка;
- боли в грудине.
Иногда, грибок аспергилла может развиваться на фоне первичной инфекции – бронхита или отита, в период снижения общего иммунитета.
Что такое инвазийное поражение Aspergillus fumigatus? Это развитие инфекции плесневого гриба, происходящее на фоне заболеваний иммунной системы.
При инвазии происходит прорастание конидий в ткани и органы, поражение распространяется по всему организму, не ограничиваясь дыхательными путями. Таким микозом плесневого гриба страдают лица, инфицированные ВИЧ, больные СПИДом, прошедшие лучевую терапию.
Виды Аспергилл
Грибы рода Aspergillus – сильные аллергены, поражающие людей с заниженной защитной функцией организма. Характеристика заболевания, вызванного аспергиллами, похожа на истинное, первичное заболевание.
Состояние не снимается при приеме стандартных противовоспалительных средств.
Диагностика
При симптомах, указывающих на наличие инфекционного или воспалительного заболевания дыхательных путей, необходимо обратиться к врачу для проведения диагностики. Диагностика проводится путем сбора анализов крови, мокрот, фрагмента слизи на посев.
Анализы на Aspergillus spp:
- ПЦР.
- Бактериальный посев.
- Микробиологическое исследование образца.
- Общий анализ крови.
- Анализ мочи.
- Мокроты из носа, при отхаркивании.
После проведения анализов, назначается лечение, состоящее из приема противогрибковых средств, противовоспалительных, антигистаминных препаратов. В каждом отдельно взятом случае, терапевтическая схема своя, зависящая от возраста, наличия первичной или вторичной инфекции, состояния иммунной и эндокринных систем, наличия онкологических заболеваний и аллергических реакций.
Терапия аспергиллеза
- Некоторые штаммы Aspergillus spp проявляют устойчивость к Итраконазолу, поэтому необходимо провести все диагностические анализы для определения возбудителя и его резистентности к препаратам. Первичная терапия может включать прием Амфотерицина В.
- При тяжелом инфицировании рекомендовано лечение аспергиллёза в условиях стационара, постоянный надзор персонала. Если иммунная система не нарушена, то большинство случаев поражения грибком aspergilles spp успешно излечиваются. При ВИЧ-инфекции прогноз неблагоприятный.
- Начальная терапия направлена на снятие воспалительного процесса и угнетения роста грибковых спор. Для терапии используют Вориканозол, Амфоцетрин В в виде инъекций. Одновременно проводится терапия антигистаминными препаратами – Зитрек, Димедрол, Кларитин и прочие.
- После стабилизации состояния больного назначается фунгицидная и фунгистатическая терапия ударного типа или классическая, в зависимости от показаний. Параллельно проводится терапия иммунодепрессантами, если необходимо.
- Заключительная терапия характеризуется укреплением полученных результатов, с приемом витаминных комплексов, препаратов укрепляющих иммунную систему. Прием противогрибковых препаратов проводится и после снятия симптоматики для предупреждения рецидива.
Ни в коем случае не нужно проводить терапию самостоятельно, назначать себе антибиотики или антимикотические средства. Это опасно для жизни.
Профилактика
Профилактические меры индивидуальны, но сводятся к простым правилам:
- укреплять иммунную систему;
- следить за состоянием жилых помещений;
- следовать правилам личной гигиены;
- защиты при земляных или черновых работах.
В случае, если лицо поражено ВИЧ-инфекцией, то для таких людей необходимо избегать работ и отдыха в зонах с грунтовыми землями, нужен постоянный контроль состояния иммунитета. Если плесень замечена на стенах старого здания в доме, следует ее обработать специальным антигрибковым составом, используя труд специалистов.
Заключение
Заболевания, которые вызывает плесень Аспергиллы, чрезвычайно опасны для организма и жизни. Инвазийные поражения для людей с угнетенной иммунной системой заканчиваются летальным исходом, для условно здоровых людей – значительным подрывом иммунитета, поражением внутренних тканей и органов.
Аспергиллез – это общее название болезней, которые вызывает этот вид плесневого грибка, поэтому не стоит недооценивать серьезность инфекции по одному источнику. Если у вас возникли симптомы, напоминающие описанные, не стоит тянуть время – обратитесь к врачу, проведите диагностику. Это сэкономит здоровье, время и деньги.
Аспергиллез — опасное грибковое заболевание, характеризующееся распространением спор плесневых грибов в различных органах и тканях. Обычно органом-мишенью становятся легкие, но могут пострадать пищеварительная система, кожные покровы, ЛОР-органы.
Заболевание смертельно опасно, но своевременно оказанная помощь может предотвратить его прогрессирование и развитие осложнений.
Особенности терапии
Заболевание имеет острое, подострое и хроническое течение, и в зависимости от этого меняются симптомы и лечение аспергиллеза. После тщательной дифференциальной диагностики необходимо выявить очаг инфекционного процесса. Если поражены легкие и процесс начался давно, может быть показано хирургическое лечение — лобэктомия (удаление части легкого).
При целесообразности консервативной терапии назначают медикаментозные препараты, направленные на устранение возбудителя, купирование симптомов, укрепление иммунитета и защиту от рецидива. Лечение занимает от 1 недели до года.
Чем можно?
Аспергиллез подразумевает комплексный подход к лечению, основу которого составляют антимикотические (противогрибковые) меры.
Форма антимикотических средств подбирается с учетом того, какой орган поражен плесневым грибом.
При аспергиллезе внутривенно назначают:
- Амфотерицин В до 1-1,5 мг/кг в сутки.
- Вориконазол.
- Каспофунгин.
Во избежание токсического действия препаратов назначают их аналоги — липосомальные формы Амфотерицина В (Амбизом, Амфолип).
Ингаляции показаны при поражении верхних дыхательных путей и легких. Для ингаляций используется препарат Амфотерицин В. Процедуру рекомендуют проводить дважды в день в течение двух недель. После недельного перерыва курс можно повторить.
Мази эффективны при кожном аспергиллезе вне зависимости от места его локализации. В форме мази выпускаются препараты Вориконазол и Амфотерицин В, которые можно использовать 1–2 раза в день.
Итраконазол выпускается в форме капсул, которые помогают избавиться от грибка и ингибируют ферменты, необходимые для роста и размножения грибка. Обычно курс лечения длится 7 дней, но в отдельных случаях его продолжительность может измениться.
При неэффективности консервативной терапии прибегают к хирургическим методам. Противогрибковые препараты не всегда способны попасть в клетки, пораженные аспергиллами, поэтому часто оперативное вмешательство оказывается неизбежным.
В экстренном порядке операцию проводят, если заболевание привело к кровотечению в легких. Обычно проводят либо удаление грибковой массы (скопление клеток грибка), либо часть легкого.
Прогноз и профилактические меры
Прогноз при аспергиллезе, к сожалению, неутешительный. Наиболее благоприятен исход при кожном поражении. Запущенные формы заболевания (септическая, инвазивная) тяжело поддаются лечению и в 80–90% случаев приводят к смерти даже при применении противогрибковых препаратов, иммуномодуляторов и гормональных средств.
Профилактика заключается в соблюдении правил личной гигиены, а также избегании мест, являющихся очевидными источниками плесени: влажные леса, пещеры, заброшенные здания, стройки, зернохранилища. Особенно это касается людей с ослабленным иммунитетом: в этом случае необходимо появляться в местах, где может быть плесень, только при острой необходимости и в медицинской маске.
Людям с угнетенными защитными силами организма рекомендуется постоянно следить за санитарно-гигиеническими условиями жилища и не выбирать профессии, связанные с высоким риском заражения аспергиллезом.
Аспергиллез — одно из самых опасных грибковых заболеваний, которое зачастую приводит к летальному исходу. Интенсивная терапия при этом недуге может продолжаться до одного года, и она включает устранение неприятных симптомов, противогрибковые мероприятия и укрепление иммунитета. При отсутствии положительной динамики показана хирургическая операция, но даже она не гарантирует выздоровления и благоприятного исхода.
Грибковые заболевания очень опасны, так как порой протекают практически без видимых признаков. Примером является аспергиллез или поражение микозом дыхательных путей. Редко затрагиваются кожные покровы, нервная система или другие внутренние органы. Патология несет угрозу для окружающих людей и легко передается. По этой причине крайне важно узнать: что это, пути передачи грибка и основные симптомы. Поставить правильный диагноз способен только пульмонолог после обследования, самолечение нередко приводит к серьезным осложнениям.
Что такое аспергиллез: виды и способы заражения
Аспергиллезом называется поражение дыхательных путей плесневыми видами грибка. В некоторых случаях патология способна вызвать осложнения или привести к смерти, если у человека диагностирован вирус иммунодефицита. Возбудитель аспергиллеза – плесневый грибок рода Aspergillus. Инвазивный тип заболевания вызывают чаще всего A. fumigatus и A. flavus, A. niger, A. terreus встречаются чуть реже, а A. glaucus, A. nidulans в единичных случаях. Всего в микробиологии насчитывается более 15 видов, способных вызывать данный недуг. Специалисты различают несколько типов болезни, среди которых:
- Бронхолегочный. Грибок напоминает трахеобронхит: человека мучает кашель, мокрота и слабость. Однако выделения имеют сероватый оттенок, состояние быстро ухудшается и патология переходит в воспаление легких. Мокрота становится зеленой и пахнет плесенью, температура тела возрастает до 39–40 градусов.
- Легочный аспергиллез в хронической или диссеминированной форме. Поражается весь организм, возбудитель оседает в лимфатических узлах и распространяется по всем системам через лимфу. Защитные функции постепенно ослабевают, поэтому заболевание плохо поддается терапии.
- Септический. Поселяется в организме у человека с ВИЧ, СПИДом или другими серьезными болезнями, при которых иммунитет не способен бороться с вирусами. Возбудители попадают во внутренние органы, вызывая поражение головного мозга, ЦНС. Во многих случаях приводит к смерти.
- Поражение ЛОР-органов. Вначале отмечается заражение грибками носоглотки, затем распространяется на внутреннее ухо и другие органы.
- Аллергический бронхолегочный аспергиллез. Считается наиболее опасным типом, так как вызывает тяжелую форму астмы и бронхоэктазии. Подвержены люди, работающие в сельскохозяйственной промышленности, на пилорамах, ткацких предприятиях или птицефабриках. КРС (крупный рогатый скот) относится к переносчикам грибка, поэтому данный фактор нельзя исключать.
- Фиброзирующий воспалительный процесс. Затрагивает костную систему, очень часто поражает череп. Диагностируется у людей, проживающих в тропическом климате.
Развивается заболевание медленно, вызывая воспалительный процесс, нагноение или кровотечения. Все изменения опасны для здоровья человека, особенно для пожилых людей и маленьких детей. К ним патология может передаться через зараженных членов семьи, которые не подозревают об инфицировании. Сильный иммунитет не позволяет развиться болезни, а вот ослабленный организм очень уязвим к различным инфекциям. Сказать точно, сколько длится инкубационный период невозможно. Все зависит от длительности контакта и иммунитета. Иногда недуг может протекать бессимптомно до 6 месяцев.
Почти во всех случаях заражение инвазивным аспергиллезом легких происходит воздушно-капельным путем, менее 10% приходится на аутоинфекцию и передачу от матери к плоду во время беременности. Зачастую отмечается первичное поражение всех дыхательных путей после вдыхания мицелия Aspergillus, реже – только пазух носа. Для инфицирования достаточно находится в зараженной местности. Через вдох грибки оседают в носовой полости, затем переходят на легкие. В запущенные случаях патология распространяется на весь организм, вызывая осложнение в виде системного грибка. Он поражает многие жизненно важные системы, вылечить его крайне трудно.
К другому пути заражения относят некоторые медицинские процедуры (бронхоскопия, пункция плевральной полости или пазух носа), если они выполнены непрофессионально. Не стоит забывать о возможности передачи нитей грибка через продукты. Мясо утки, курицы, молоко или хлеб могут быть инфицированы. Врачи придерживаются мнения, что аспергиллез кожи передается окружающим людям, на теле которых есть царапины или раны.
Провоцирующие факторы
Спровоцировать возникновение болезни могут вмешательства в организм и некоторые заболевания. Доктора говорят, что благоприятно на размножении грибка влияет жаркий влажный климат, курение, а также длительное нахождение в больницах. По последний причине часто аллергический аспергиллез диагностируется у больных раком людей, которые перенесли химиотерапию и вынуждены долгое время пребывать в стационаре. Помимо этого развивается недуг при:
- злокачественных опухолях и раке крови;
- сахарном диабете и аутоиммунных заболеваниях;
- длительном приеме кортикостероидов;
- хирургических вмешательствах;
- ожогах верхних дыхательных путей;
- иммунодефиците человека, СПИДе;
- хронических патологиях легких (астма, бронхит и т.п.).
Генетический фактор также важен, однако патология не передается от родителей к ребенку (исключение – заражение плода от больной матери). Малышу может достаться ослабленный иммунитет и нарушенная функция органов дыхания. Опасность представляют птицы, домашние питомцы и скот. Аспергиллез у собак, кошек, уток, кур, кроликов, бройлеров наблюдается чаще, чем у людей. К человеку инфекция переходит после общения с зараженными любимцами или употребления мяса, молока, сыра.
Симптомы заболевания
Характерные признаки заражения нередко долго не проявляются, они могут маскироваться под обычную простуду или грипп. Аллергический аспергиллез сопровождается повышением температуры тела до 38 градусов и сильным кашлем (при тяжелой форме отходит гнойная слизь или кровь). Если ранее была выявлена астма, то приступы становятся чаще и сильнее. Бронхолегочный тип с грибковой массой определяют по боли в грудной клетке, сильной слабости, резкому снижению веса, одышке и кашлю с мокротой. Поражение ЛОР-органов вызывает нарушение носового дыхания и заложенность, прозрачный или белесый насморк, боли в голове. На осмотре доктор может выявить полипы в полости носа и слизь.
Системная грибковая инфекция вызывает изменения практически во всем организме. Дышать становится больно, температура поднимается до 40 градусов, во время кашля начинается кровотечение. Кроме того, отмечается отечность лица, высыпания по телу, сиплый голос и болезненные ощущения в суставах. Состояние подавленное, аппетит и сон нарушены.
Аспергиллез – микоз, вызываемый различными видами плесневых грибков рода Aspergillus и протекающий с хроническими токсико-аллергическими проявлениями. При аспергиллезе преимущественно поражается бронхолегочная система и придаточные пазухи; реже — кожа, зрительная система, ЦНС и др. У больных с низкой иммунной реактивностью может развиваться диссеминированный аспергиллез. Ведущую роль в диагностике аспергиллеза играют лабораторные методы: микроскопия, бакпосев, серологические реакции, ПЦР. Возможна постановка ингаляционных и кожно-аллергических проб. Лечение аспергиллеза проводится антифунгальными препаратами.
Общие сведения
Аспергиллез – грибковое заболевание, возбудителем которого выступают плесневые грибы аспергиллы. Аспергиллы могут вызывать разнообразные поверхностные и глубокие микозы внутренних органов, кожи и слизистых оболочек, поэтому аспергиллез изучается в рамках целого ряда клинических дисциплин: микологии, пульмонологии, отоларингологии, дерматологии, офтальмологии и др. За последние два десятилетия частота заражения аспергиллезом в популяции выросла на 20%, что связано с увеличением числа пациентов с врожденным и приобретенным иммунодефицитом, распространением наркомании и ВИЧ-инфекции, нерациональным использованием антибиотиков, применением иммуносупрессивных препаратов в онкологии и трансплантологии. Все это еще раз подтверждает растущую актуальность аспергиллеза.
Причины аспергиллеза
Возбудителями аспергиллеза у человека могут выступать следующие виды плесневых грибков рода Aspergillus: A. flavus, A. Niger, A. Fumigatus, A. nidulans. A. terreus, A. clavatus. Аспергиллы являются аэробами и гетеротрофами; способны расти при температуре до 50°С, длительно сохраняться при высушивании и замораживании. В окружающей среде аспергиллы распространены повсеместно – в почве, воздухе, воде. Благоприятные условия для роста и размножения аспергилл имеются в вентиляционных и душевых системах, кондиционерах и увлажнителях воздуха, старых вещах и книгах, сырых стенах и потолках, длительно хранящихся пищевых продуктах, сельскохозяйственных и комнатных растениях и др.
Заражение аспергиллезом чаще всего происходит ингаляционным путем при вдыхании частиц пыли, содержащих мицелий гриба. Наибольшему риску возникновения заболевания подвержены сельскохозяйственные рабочие, работники бумагопрядильных и ткацких предприятий, мукомолы, а также заводчики голубей, поскольку голуби, чаще других птиц, болеют аспергиллезом. Возникновению грибковой инфекции способствует инфицирование при проведении инвазивных процедур: бронхоскопии, пункции околоносовых пазух, эндоскопической биопсии и др. Не исключен контактный путь передачи аспергиллеза через поврежденные кожные покровы и слизистые оболочки. Также возможно алиментарное инфицирование при употреблении контаминированных аспергиллами продуктов питания (например, куриного мяса).
Кроме экзогенного инфицирования аспергиллами, известны случаи аутозаражения (при активации грибков, обитающих на коже, слизистой зева и дыхательных путей) и трансплацентарного инфицирования. К факторам риска заболеваемости аспергиллезом относятся иммунодефициты любого генеза, хронические заболевания дыхательной системы (ХОБЛ, туберкулез, бронхоэктатическая болезнь, бронхиальная астма и др.), сахарный диабет, дисбактериоз, ожоговые травмы; прием антибиотиков, кортикостероидов и цитостатиков, проведение лучевой терапии. Нередки случаи развития микозов смешанной этиологии, вызываемых различными видами грибков – аспергиллами, кандида, актиномицетами.
Классификация аспергиллеза
Таким образом, в зависимости от путей распространения грибковой инфекции различают эндогенный (аутоинфекцию), экзогенный (с воздушно-капельным и алиментарным путем передачи) и трансплацентарный аспергиллез (с вертикальным путем заражения).
По локализации патологического процесса выделяют следующие формы аспергиллеза: бронхолегочную (в т. ч. аспергиллез легких), ЛОР-органов, кожную, глазную, костную, септическую (генерализованную) и пр. На первичное поражение респираторного тракта и легких приходится около 90% всех случаев аспергиллеза; придаточных пазух носа – 5%. Вовлечение остальных органов диагностируются менее чем у 5% больных; диссеминация аспергиллеза развивается примерно в 30% случаев, преимущественно, у ослабленных лиц с отягощенным преморбидным фоном.
Симптомы аспергиллеза
Наиболее изученной на сегодняшний день формой патологии является аспергиллез легких. Начальные стадии бронхолегочного аспергиллеза маскируются под клинику трахеобронхита или бронхита. Больных беспокоит кашель с мокротой сероватого цвета, кровохарканье, общая слабость, похудение. При распространении процесса на легкие развивается легочная форма микоза — аспергиллезная пневмония. В острой фазе отмечается лихорадка неправильного типа, ознобы, кашель с обильной слизисто-гнойной мокротой, одышка, боли в грудной клетке. При дыхании изо рта может ощущаться запах плесени. С помощью микроскопического исследования мокроты обнаруживаются колонии мицелия и споры аспергилл.
У больных с сопутствующими заболеваниями дыхательной системы (легочным фиброзом, эмфиземой, кистами, абсцессом легкого, саркоидозом, туберкулезом, гипоплазией, гистоплазмозом) нередко формируется аспергиллома легких – инкапсулированный очаг, содержащий гифы гриба, фибрин, слизь и клеточные элементы. Гибель пациентов с аспергилломой может наступить в результате легочного кровотечения или асфиксии.
Аспергиллез ЛОР-органов может протекать в виде наружного или среднего отита, ринита, синусита, тонзиллита, фарингита. При аспергиллезном отите вначале возникает гиперемия, шелушение и зуд кожи наружного слухового прохода. С течением времени слуховой проход заполняется рыхлой сероватой массой, содержащей нити и споры гриба. Возможно распространение аспергиллеза на барабанную перепонку, сопровождающееся резкими колющими болями в ухе. Описаны поражения верхнечелюстных и клиновидных пазух, решетчатой кости, переход грибковой инвазии на орбиты. Глазной аспергиллез может принимать форму конъюнктивита, язвенного блефарита, узелкового кератита, дакриоцистита, блефаромейбомита, панофтальмита. Нередки осложнения в виде глубоких язв роговицы, увеита, глаукомы, потери зрения.
Аспергиллез кожи характеризуется появлением эритемы, инфильтрации, коричневатых чешуек, умеренного зуда. В случае развития онихомикоза возникает деформация ногтевых пластин, изменение цвета на темно-желтый или коричневато-зеленоватый, крошение ногтей. Аспергиллез ЖКТ протекает под видом эрозивного гастрита или энтероколита: для него типичны запах плесени изо рта, тошнота, рвота, диарея.
Генерализованная форма аспергиллеза развивается при гематогенной диссеминации аспергилл из первичного очага в различные органы и ткани. При данной форме заболевания возникают аспергиллезный эндокардит, менингит, энцефалит; абсцессы головного мозга, почек, печени, миокарда; поражение костей, ЖКТ, ЛОР-органов; аспергиллезный сепсис. Летальность от септической формы аспергиллеза очень высока.
Диагностика аспергиллеза
В зависимости от формы микоза пациенты направляются на консультацию к специалисту соответствующего профиля: пульмонологу, отоларингологу, офтальмологу, микологу. В процессе диагностики аспергиллеза большое внимание уделяется анамнезу, в т. ч. профессиональному, наличию хронической легочной патологии и иммунодефицита. При подозрении на бронхолегочную форму аспергиллеза проводится рентгенография и КТ легких, бронхоскопия с забором мокроты, бронхоальвеолярный лаваж.
Основу диагностики аспергиллеза составляет комплекс лабораторных исследований, материалом для которых могут служить мокрота, промывные воды из бронхов, соскобы с гладкой кожи и ногтей, отделяемое из пазух носа и наружного слухового прохода, отпечатки с поверхности роговицы, кал и пр. Аспергиллы могут быть обнаружены с помощью микроскопии, культурального исследования, ПЦР, серологических реакций (ИФА, РСК, РИА). Возможно проведение кожно-аллергических проб с антигенами аспергилл.
Дифференциальная диагностика аспергиллеза легких проводится с воспалительными заболеваниями респираторного тракта вирусной или бактериальной этиологии, саркоидозом, кандидозом, туберкулезом легких, муковисцидозом, опухолями легких и др. Аспергиллез кожи и ногтей имеет сходство с эпидермофитией, рубромикозом, сифилисом, туберкулезом, актиномикозом.
Лечение аспергиллеза
В зависимости от тяжести состояния пациента и формы аспергиллеза лечение может осуществляться в амбулаторных условиях или в стационаре соответствующего профиля. Антифунгальная терапия проводится препаратами: амфотерицин В, вориконазол, итраконазол, флуцитозин, каспофунгин. Противогрибковые препараты могут назначаться внутрь, внутривенно, в виде ингаляций. При аспергиллезе кожи, ногтей и слизистых оболочек проводится местная обработка очагов противогрибковыми средствами, антисептиками, ферментами. Противогрибковая терапия продолжается от 4 до 8 недель, иногда — до 3-х месяцев и дольше.
При аспергилломе легких показана хирургическая тактика – экономная резекция легкого или лобэктомия. В процессе лечения любой формы аспергиллеза необходимо проведение стимулирующей и иммунокорригирующей терапии.
Наиболее благоприятное течение отмечается при аспергиллезе кожи и слизистых оболочек. Летальность от легочных форм микоза составляет 20-35%, а у лиц с иммунодефицитом – до 50%. Септическая форма аспергиллеза имеет неблагоприятный прогноз. К мерам, позволяющим предупредить заражение аспергиллезом, относятся мероприятия по улучшению санитарно-гигиенических условий: борьба с пылью на производстве, ношение работниками мельниц, зернохранилищ, овощехранилищ, ткацких предприятий индивидуальных средств защиты (респираторов), улучшение вентиляции цехов и складов, регулярное микологическое обследование лиц из групп риска.